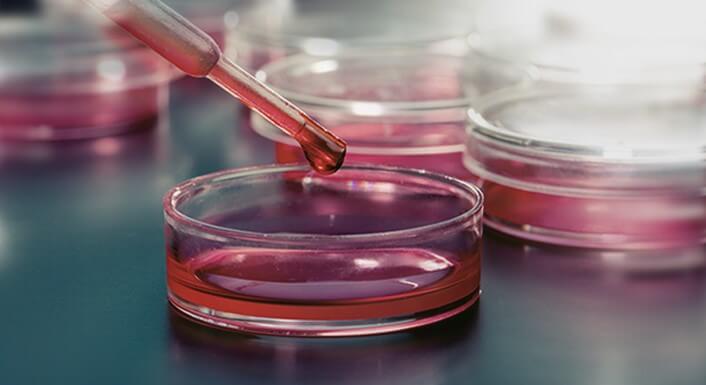

이번 글에서는 미생물배양배지를 생산하고 판매하는 사업을 영위하며 제약, 바이오 등 다양한 분야의 사업을 영위하고 있는 시너지이노베이션 주가 배당금 지급일 등 주요 기업 정보에 대해 알아보도록 하겠습니다.

목차
1. 시너지이노베이션 주가
2. 시너지이노베이션 배당금 지급일 배당락일
3. 시너지이노베이션 어떤 기업인가?
1. 시너지이노베이션 주가
시너지이노베이션의 최근 5년 주가는 2020년 4월 최저가 1,525원에서 반등해 2021년 하반기부터 상승세를 보였으며, 2021년 7월에는 최고가 6,630원을 기록했습니다. 이는 체외진단·바이오 관련 테마에 대한 투자자들의 기대감이 집중된 시기였습니다.
이후 실적 정체와 관련 업종의 전반적인 조정 흐름 속에 주가는 점진적인 하락세를 보였으며, 장기간 횡보세를 이어갔습니다. 그러나 2025년 4월 들어 5 거래일 연속 상한가를 기록하며 4,015원까지 급등했으며, 이는 최근 수급 변화나 신규 사업 재부각 등 단기 모멘텀이 작용한 결과로 분석됩니다.
2. 시너지이노베이션 배당금 지급일 배당락일
시너지이노베이션은 매년 매출액이 증가추세를 그리며 좋은 흐름을 보이고 있지만 많은 연구개발 비용으로 현재 배당금은 지급되지 못하고 있습니다.
3. 시너지이노베이션 어떤 기업인가?
시너지이노베이션은 바이오 융합 기술을 바탕으로 의료, 건강기능식품, 진단 및 치료 보조 기술을 개발·제조하는 헬스케어 전문 기업입니다. 4차 산업혁명 시대에 발맞춰 정밀의학, 예방의학의 중요성이 커지는 가운데, 다양한 바이오 기반 제품군을 통해 개인 맞춤형 건강관리 시장을 선도하고 있습니다.

바이오기술 부문
시너지이노베이션은 국내 최초로 120여 종의 미생물배양용 배지를 생산하고 판매하는 사업을 영위하고 있습니다. 전국의 병원, 검사센터, 제약회사 등 다양한 곳에 납품하며 성장을 이어가고 있습니다.

의료 부문
의료 분야에서는 피부재생, 항노화, 통증 완화 등을 목적으로 하는 다양한 의료기기와 생체 소재 제품을 개발하고 있으며, 병·의원 및 전문 의료기관과 협업하여 실제 임상에서 활용 가능한 제품 상용화에 집중하고 있습니다. 인체 적용 안전성과 효과를 입증받은 제품을 중심으로 글로벌 시장 진출도 확대 중입니다.



건강기능식품 부문
시너지이노베이션은 기능성 소재 연구와 인체 적용 데이터를 기반으로 한 건강기능식품 브랜드를 운영하고 있으며, 면역력 증진, 간 건강, 혈당 조절 등을 지원하는 제품을 출시하고 있습니다. 식약처 기능성 인증을 받은 원료와 자체 특허 성분을 바탕으로 소비자 맞춤형 건강 관리 제품을 꾸준히 확대하고 있습니다.



결론
이상으로 시너지이노베이션 주가 배당금 지급일 등 주요 기업 정보에 대해 알아보았습니다.
'2025년 배당금' 카테고리의 다른 글
| 제우스 주가 배당금 지급일 / 2025년 최신정보 (1) | 2025.04.18 |
|---|---|
| 테스 주가 배당금 지급일 / 2025년 최신정보 (0) | 2025.04.17 |
| 인카금융서비스 주가 배당금 지급일 / 2025년 최신정보 (0) | 2025.04.17 |
| 유바이오로직스 주가 배당금 지급일 배당락일 / 2025년 최신정보 (0) | 2025.04.16 |
| 지노믹트리 주가 배당금 지급일 / 2025년 최신정보 (0) | 2025.04.15 |
| 비보존제약 주가 배당금 지급일 / 2025년 최신정보 (0) | 2025.04.15 |
| 네오셈 주가 배당금 지급일 / 2025년 최신정보 (0) | 2025.04.15 |
| 로보티즈 주가 배당금 지급일 배당일 / 2025년 최신정보 (0) | 2025.04.14 |
